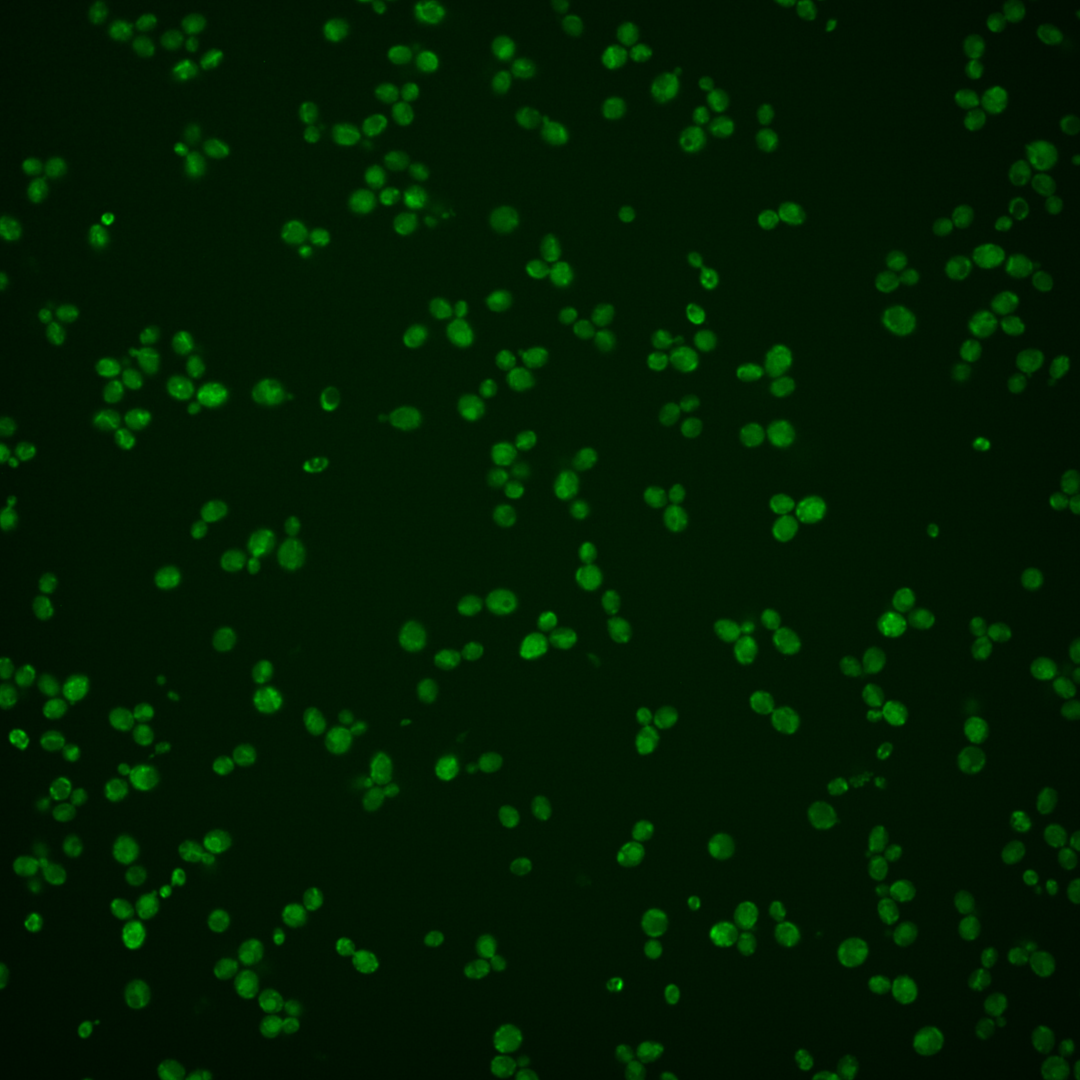
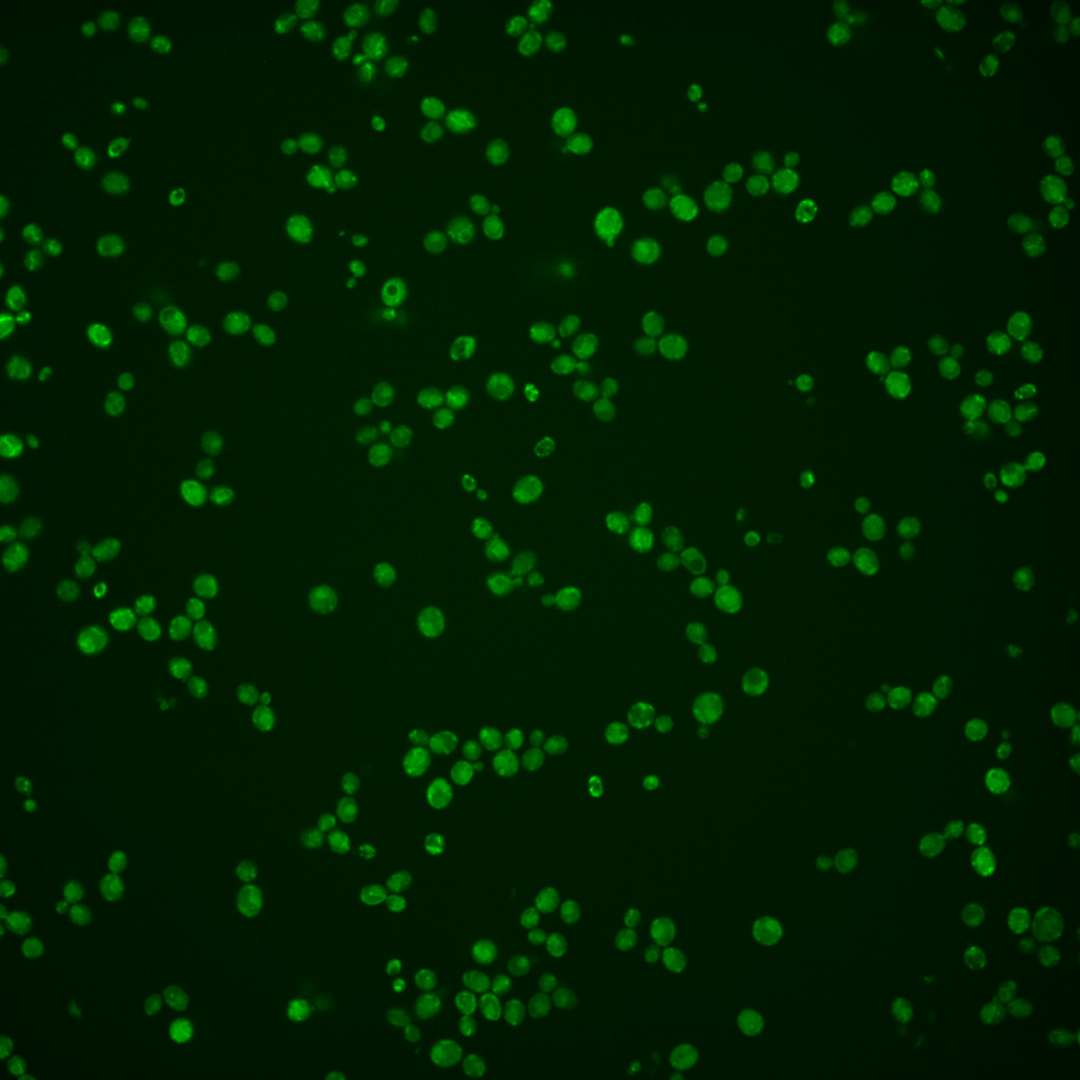
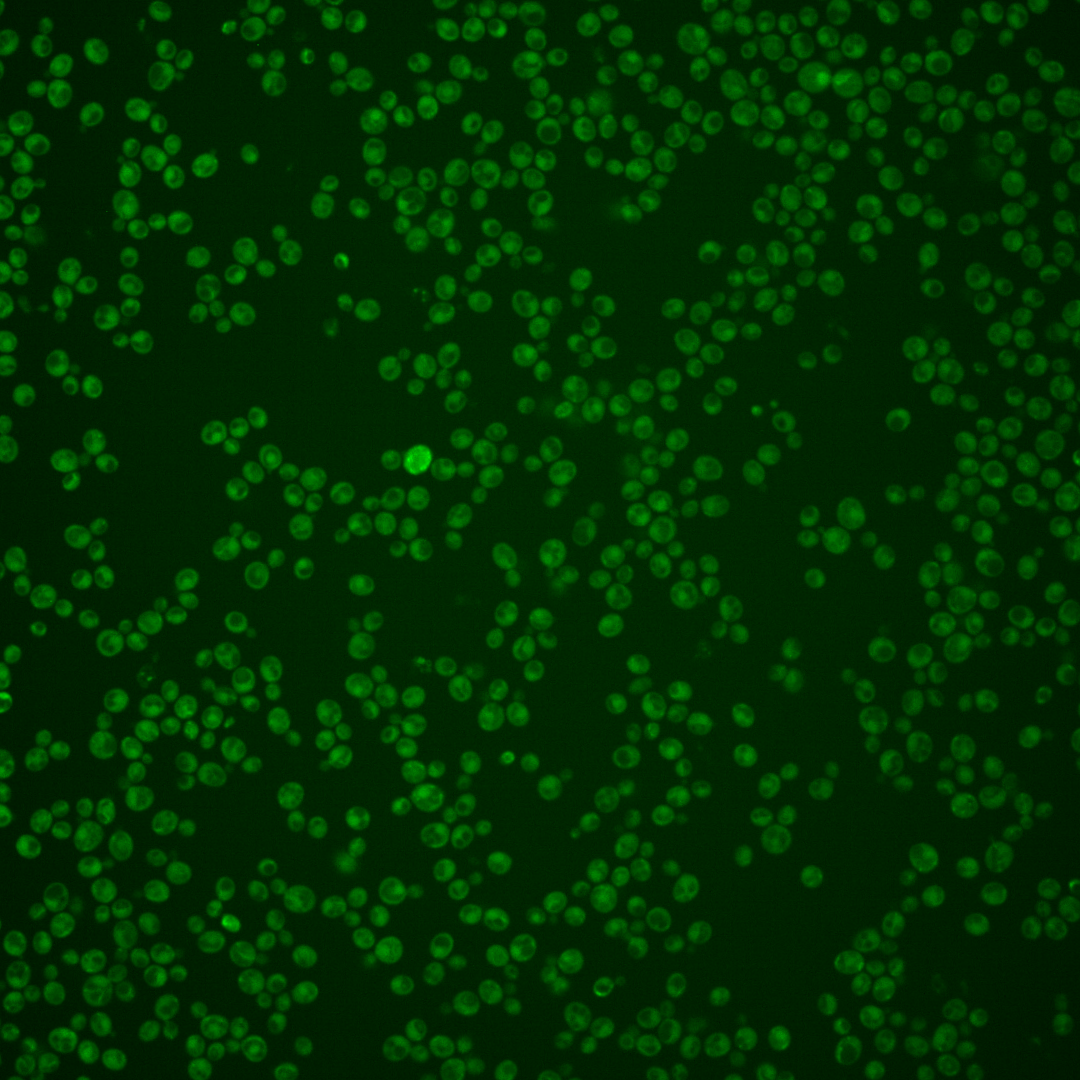

| Standard name | |
|---|---|
| Human Ortholog | |
| Description | Phospholipase B (lysophospholipase) involved in lipid metabolism; hydrolyzes phosphatidylinositol and phosphatidylserine and displays transacylase activity in vitro; PLB3 has a paralog, PLB1, that arose from the whole genome duplication |
Micrographs




















































































Sub-cellular Localization
Yeast GFP Assignment
Protein Abundance
Localization Change
External localization resources
| ensLOC | DeepLoc | |||||||||||||||||||||||
|---|---|---|---|---|---|---|---|---|---|---|---|---|---|---|---|---|---|---|---|---|---|---|---|---|
| Localization | WT1 | WT2 | WT3 | RAP60 | RAP140 | RAP220 | RAP300 | RAP380 | RAP460 | RAP540 | RAP620 | RAP700 | HU80 | HU120 | HU160 | rpd3Δ_1 | rpd3Δ_2 | rpd3Δ_3 | WT1 | WT2 | WT3 | AF100 | AF140 | AF180 |
| Cortical Patches | 0 | 5 | 0 | 4 | 4 | 1 | 2 | 2 | 1 | 1 | 3 | 0 | 1 | 1 | 1 | 1 | 1 | 0 | 2 | 0 | 6 | 0 | 2 | 0 |
| Bud | 0 | 2 | 0 | 3 | 4 | 7 | 22 | 37 | 11 | 25 | 39 | 29 | 0 | 0 | 1 | 0 | 0 | 0 | 4 | 9 | 8 | 1 | 3 | 4 |
| Bud Neck | 0 | 0 | 0 | 0 | 0 | 0 | 1 | 2 | 0 | 0 | 0 | 0 | 0 | 0 | 0 | 0 | 0 | 0 | 1 | 2 | 2 | 1 | 1 | 0 |
| Bud Site | 0 | 0 | 0 | 0 | 0 | 2 | 0 | 4 | 3 | 1 | 0 | 1 | 0 | 0 | 1 | 0 | 0 | 0 | – | – | – | – | – | – |
| Cell Periphery | 0 | 0 | 2 | 0 | 2 | 3 | 3 | 4 | 1 | 1 | 3 | 2 | 1 | 1 | 1 | 1 | 0 | 0 | 0 | 1 | 0 | 0 | 0 | 0 |
| Cytoplasm | 183 | 241 | 159 | 200 | 222 | 233 | 307 | 464 | 274 | 398 | 324 | 382 | 22 | 91 | 164 | 131 | 72 | 87 | 51 | 70 | 26 | 7 | 13 | 24 |
| Endoplasmic Reticulum | 7 | 20 | 13 | 1 | 13 | 5 | 3 | 7 | 1 | 4 | 5 | 1 | 4 | 9 | 3 | 16 | 4 | 12 | 15 | 14 | 23 | 17 | 27 | 37 |
| Endosome | 5 | 0 | 27 | 30 | 88 | 71 | 123 | 65 | 21 | 20 | 10 | 14 | 1 | 0 | 2 | 4 | 9 | 6 | 6 | 13 | 33 | 15 | 22 | 14 |
| Golgi | 2 | 0 | 1 | 3 | 3 | 1 | 0 | 0 | 0 | 0 | 0 | 0 | 0 | 0 | 0 | 1 | 0 | 4 | 1 | 2 | 9 | 6 | 14 | 10 |
| Mitochondria | 2 | 33 | 13 | 22 | 30 | 109 | 166 | 266 | 168 | 243 | 252 | 217 | 0 | 1 | 0 | 8 | 4 | 5 | 28 | 35 | 51 | 14 | 28 | 28 |
| Nucleus | 1 | 1 | 0 | 0 | 0 | 3 | 4 | 13 | 2 | 4 | 2 | 1 | 1 | 1 | 0 | 61 | 26 | 30 | 0 | 1 | 0 | 0 | 0 | 0 |
| Nuclear Periphery | 0 | 1 | 0 | 0 | 0 | 0 | 2 | 3 | 1 | 1 | 0 | 2 | 0 | 1 | 0 | 0 | 0 | 0 | 2 | 0 | 0 | 1 | 1 | 0 |
| Nucleolus | 0 | 0 | 0 | 0 | 3 | 3 | 15 | 17 | 3 | 1 | 3 | 0 | 0 | 0 | 0 | 0 | 0 | 0 | 0 | 0 | 0 | 0 | 0 | 0 |
| Peroxisomes | 0 | 0 | 2 | 3 | 1 | 0 | 9 | 2 | 1 | 2 | 1 | 3 | 0 | 0 | 0 | 0 | 0 | 0 | 0 | 0 | 0 | 0 | 0 | 0 |
| SpindlePole | 0 | 0 | 0 | 2 | 5 | 5 | 17 | 17 | 8 | 11 | 6 | 18 | 0 | 0 | 0 | 0 | 0 | 0 | 0 | 6 | 2 | 2 | 0 | 1 |
| Vac/Vac Membrane | 61 | 51 | 49 | 30 | 121 | 86 | 90 | 107 | 49 | 73 | 50 | 42 | 5 | 13 | 17 | 192 | 124 | 199 | 140 | 216 | 119 | 59 | 155 | 148 |
| Unique Cell Count | 236 | 322 | 237 | 268 | 426 | 457 | 632 | 849 | 459 | 637 | 540 | 575 | 32 | 116 | 181 | 304 | 183 | 269 | 259 | 381 | 290 | 132 | 274 | 275 |
| Labelled Cell Count | 261 | 354 | 266 | 298 | 496 | 529 | 764 | 1010 | 544 | 785 | 698 | 712 | 35 | 118 | 190 | 415 | 240 | 343 | 259 | 381 | 290 | 132 | 274 | 275 |
Yeast GFP Assignment
Protein Abundance
| Screen | WT1 | WT2 | WT3 | RAP60 | RAP140 | RAP220 | RAP300 | RAP380 | RAP460 | RAP540 | RAP620 | RAP700 | HU80 | HU120 | HU160 | rpd3Δ_1 | rpd3Δ_2 | rpd3Δ_3 | AF100 | AF140 | AF180 |
|---|---|---|---|---|---|---|---|---|---|---|---|---|---|---|---|---|---|---|---|---|---|
| Mean Cell GFP Intensity (1e-4) | 5.3 | 4.8 | 5.9 | 6.4 | 6.0 | 5.4 | 4.8 | 4.6 | 4.3 | 3.8 | 3.9 | 3.7 | 7.3 | 6.3 | 6.3 | 7.2 | 8.7 | 10.4 | 9.4 | 9.2 | 9.0 |
| Std Deviation (1e-4) | 1.6 | 1.3 | 2.3 | 2.9 | 2.3 | 2.4 | 1.9 | 1.7 | 1.6 | 1.3 | 1.3 | 1.1 | 1.6 | 1.3 | 1.3 | 2.2 | 3.0 | 3.1 | 2.2 | 2.2 | 2.1 |
| Intensity Change (Log2) | – | – | – | 0.11 | 0.01 | -0.13 | -0.31 | -0.38 | -0.48 | -0.65 | -0.6 | -0.68 | 0.3 | 0.08 | 0.09 | 0.28 | 0.55 | 0.81 | 0.66 | 0.63 | 0.59 |
Localization Change
| Localization | RAP60 | RAP140 | RAP220 | RAP300 | RAP380 | RAP460 | RAP540 | RAP620 | RAP700 | HU80 | HU120 | HU160 | rpd3Δ_1 | rpd3Δ_2 | rpd3Δ_3 |
|---|---|---|---|---|---|---|---|---|---|---|---|---|---|---|---|
| Actin | – | – | – | – | – | – | – | – | – | – | – | – | – | – | – |
| Bud | – | – | – | – | – | – | – | – | – | – | – | – | 0 | 0 | 0 |
| Bud Neck | – | – | – | – | – | – | – | – | – | – | – | – | 0 | 0 | 0 |
| Bud Site | – | – | – | – | – | – | – | – | – | – | – | – | 0 | 0 | 0 |
| Cell Periphery | – | – | – | – | – | – | – | – | – | – | – | – | 0 | 0 | 0 |
| Cyto | – | – | – | – | – | – | – | – | – | – | – | – | – | – | – |
| Endoplasmic Reticulum | – | – | – | – | – | – | – | – | – | – | – | – | 0 | 0 | 0 |
| Endosome | – | – | – | – | – | – | – | – | – | – | – | – | 0 | 0 | 0 |
| Golgi | – | – | – | – | – | – | – | – | – | – | – | – | 0 | 0 | 0 |
| Mitochondria | – | – | – | – | – | – | – | – | – | – | – | – | 0 | 0 | 0 |
| Nuclear Periphery | – | – | – | – | – | – | – | – | – | – | – | – | 0 | 0 | 0 |
| Nuc | – | – | – | – | – | – | – | – | – | – | – | – | – | – | – |
| Nucleolus | – | – | – | – | – | – | – | – | – | – | – | – | 0 | 0 | 0 |
| Peroxisomes | – | – | – | – | – | – | – | – | – | – | – | – | 0 | 0 | 0 |
| SpindlePole | – | – | – | – | – | – | – | – | – | – | – | – | 0 | 0 | 0 |
| Vac | – | – | – | – | – | – | – | – | – | – | – | – | – | – | – |
| Cortical Patches | – | – | – | – | – | – | – | – | – | – | – | – | 0 | 0 | 0 |
| Cytoplasm | – | – | – | – | – | – | – | – | – | – | – | – | 0 | 0 | 0 |
| Nucleus | – | – | – | – | – | – | – | – | – | – | – | – | 0 | 0 | 0 |
| Vacuole | – | – | – | – | – | – | – | – | – | – | – | – | 9.9 | 9.7 | 12.0 |
External localization resources
Images






























Protein Concentration and Protein Localization Data
| R1 | R2 | R3 | ||||||||||||||||
|---|---|---|---|---|---|---|---|---|---|---|---|---|---|---|---|---|---|---|
| G1 Pre-START | G1 Post-START | S/G2 | Metaphase | Anaphase | Telophase | G1 Pre-START | G1 Post-START | S/G2 | Metaphase | Anaphase | Telophase | G1 Pre-START | G1 Post-START | S/G2 | Metaphase | Anaphase | Telophase | |
| Concentration | 7.8149 | 12.3093 | 9.6838 | 7.1204 | 7.105 | 10.5118 | 8.4255 | 10.7558 | 10.454 | 11.7547 | 7.699 | 11.0926 | 9.7667 | 13.0924 | 11.0621 | 8.795 | 9.6101 | 11.9068 |
| Actin | 0.0333 | 0.0019 | 0.0099 | 0.0112 | 0.0678 | 0.0088 | 0.0313 | 0.0016 | 0.0074 | 0.0044 | 0.0041 | 0.0009 | 0.0127 | 0.003 | 0.0054 | 0.0025 | 0.002 | 0.0018 |
| Bud | 0.0019 | 0.0021 | 0.0043 | 0.0018 | 0.0044 | 0.0017 | 0.0017 | 0.0021 | 0.0039 | 0.0084 | 0.0067 | 0.0043 | 0.0016 | 0.004 | 0.0038 | 0.0061 | 0.0084 | 0.0012 |
| Bud Neck | 0.0013 | 0.0011 | 0.0027 | 0.0016 | 0.0014 | 0.0095 | 0.0014 | 0.0014 | 0.0038 | 0.002 | 0.0058 | 0.0032 | 0.0023 | 0.0035 | 0.0032 | 0.0064 | 0.0021 | 0.0068 |
| Bud Periphery | 0.0029 | 0.0022 | 0.0056 | 0.0035 | 0.0043 | 0.0029 | 0.0027 | 0.0037 | 0.0058 | 0.0184 | 0.015 | 0.0076 | 0.0028 | 0.0063 | 0.0068 | 0.0265 | 0.0106 | 0.0025 |
| Bud Site | 0.0033 | 0.0041 | 0.0108 | 0.0019 | 0.0021 | 0.001 | 0.0055 | 0.0084 | 0.0086 | 0.0032 | 0.0026 | 0.0028 | 0.011 | 0.0101 | 0.0041 | 0.0027 | 0.0022 | 0.0007 |
| Cell Periphery | 0.0016 | 0.0017 | 0.0021 | 0.0019 | 0.001 | 0.0009 | 0.0027 | 0.0023 | 0.0079 | 0.0026 | 0.0013 | 0.0019 | 0.0035 | 0.006 | 0.0092 | 0.0042 | 0.0017 | 0.0015 |
| Cytoplasm | 0.0847 | 0.2617 | 0.1743 | 0.1346 | 0.0498 | 0.0978 | 0.1097 | 0.2109 | 0.2112 | 0.1296 | 0.1389 | 0.1131 | 0.1067 | 0.2273 | 0.2327 | 0.172 | 0.1777 | 0.1697 |
| Cytoplasmic Foci | 0.0279 | 0.0197 | 0.0251 | 0.0194 | 0.033 | 0.0199 | 0.055 | 0.0174 | 0.025 | 0.0136 | 0.045 | 0.0167 | 0.0295 | 0.018 | 0.0239 | 0.0262 | 0.0285 | 0.0233 |
| Eisosomes | 0.0003 | 0 | 0.0001 | 0.0001 | 0.0006 | 0.0001 | 0.0003 | 0 | 0.0001 | 0 | 0 | 0 | 0.0001 | 0 | 0.0001 | 0.0001 | 0 | 0 |
| Endoplasmic Reticulum | 0.0834 | 0.0638 | 0.0738 | 0.0472 | 0.0422 | 0.0707 | 0.1098 | 0.119 | 0.098 | 0.06 | 0.0428 | 0.1329 | 0.1338 | 0.1266 | 0.1247 | 0.1498 | 0.0455 | 0.1832 |
| Endosome | 0.2964 | 0.2721 | 0.2298 | 0.2684 | 0.2724 | 0.3372 | 0.3161 | 0.2292 | 0.219 | 0.2951 | 0.2359 | 0.3069 | 0.2957 | 0.1723 | 0.2041 | 0.2815 | 0.2869 | 0.2754 |
| Golgi | 0.0443 | 0.0289 | 0.0349 | 0.0253 | 0.0183 | 0.0384 | 0.0484 | 0.0234 | 0.0438 | 0.0392 | 0.0523 | 0.0481 | 0.0412 | 0.0239 | 0.0422 | 0.0389 | 0.0222 | 0.0364 |
| Lipid Particles | 0.0174 | 0.0067 | 0.0042 | 0.0045 | 0.0086 | 0.004 | 0.013 | 0.0043 | 0.0047 | 0.0009 | 0.0076 | 0.0077 | 0.0142 | 0.0117 | 0.0036 | 0.0025 | 0.0011 | 0.0039 |
| Mitochondria | 0.0597 | 0.0201 | 0.0279 | 0.042 | 0.0094 | 0.0272 | 0.0255 | 0.0581 | 0.0192 | 0.0713 | 0.0232 | 0.0244 | 0.0285 | 0.0084 | 0.0221 | 0.0263 | 0.0062 | 0.0241 |
| None | 0.0071 | 0.0005 | 0.0054 | 0.0008 | 0.002 | 0.0006 | 0.0043 | 0.0021 | 0.0013 | 0.0006 | 0.0008 | 0.0131 | 0.0114 | 0.0011 | 0.0024 | 0.0008 | 0.0004 | 0.0006 |
| Nuclear Periphery | 0.023 | 0.0117 | 0.019 | 0.0252 | 0.0181 | 0.0244 | 0.025 | 0.0183 | 0.0154 | 0.0119 | 0.0093 | 0.0215 | 0.0433 | 0.0279 | 0.022 | 0.0125 | 0.0121 | 0.024 |
| Nucleolus | 0.0006 | 0.0002 | 0.0003 | 0.0003 | 0.0004 | 0.0002 | 0.0004 | 0.0003 | 0.0006 | 0.0003 | 0.0004 | 0.0012 | 0.0015 | 0.001 | 0.0003 | 0.0003 | 0.0003 | 0.0001 |
| Nucleus | 0.004 | 0.0029 | 0.0032 | 0.0049 | 0.0027 | 0.003 | 0.0037 | 0.0032 | 0.0043 | 0.0027 | 0.003 | 0.004 | 0.0053 | 0.0049 | 0.0038 | 0.003 | 0.0025 | 0.0031 |
| Peroxisomes | 0.0079 | 0.0002 | 0.0049 | 0.0016 | 0.0121 | 0.001 | 0.0142 | 0.0002 | 0.0005 | 0.0003 | 0.0042 | 0.0002 | 0.0052 | 0.0004 | 0.0004 | 0.0005 | 0.0004 | 0.0005 |
| Punctate Nuclear | 0.0026 | 0.0002 | 0.0013 | 0.0005 | 0.0137 | 0.0002 | 0.0022 | 0.0004 | 0.0004 | 0.0001 | 0.0004 | 0.0005 | 0.0011 | 0.0005 | 0.0003 | 0.0003 | 0.0002 | 0.0003 |
| Vacuole | 0.2262 | 0.2406 | 0.2643 | 0.3342 | 0.3241 | 0.2585 | 0.1864 | 0.2465 | 0.2635 | 0.2165 | 0.31 | 0.2207 | 0.2003 | 0.2965 | 0.2378 | 0.1893 | 0.3202 | 0.1859 |
| Vacuole Periphery | 0.0701 | 0.0574 | 0.096 | 0.069 | 0.1117 | 0.0921 | 0.0406 | 0.0472 | 0.0557 | 0.1189 | 0.0907 | 0.0681 | 0.0484 | 0.0467 | 0.0469 | 0.0479 | 0.0688 | 0.0549 |
Sequencing Data
| R1 | R2 | |||||||||
|---|---|---|---|---|---|---|---|---|---|---|
| G1 Post-START | S/G2 | Metaphase | Anaphase | Telophase | G1 Post-START | S/G2 | Metaphase | Anaphase | Telophase | |
| Gene Expression | 25.6979 | 14.8363 | 28.4108 | 37.9979 | 23.6006 | 29.4292 | 22.5015 | 23.8419 | 26.5102 | 31.5656 |
| Translational Efficiency | 0.6199 | 0.3316 | 0.3029 | 0.5832 | 0.6387 | 0.7522 | 0.194 | 0.1619 | 0.3899 | 0.28 |
Hit Data
| Dataset | Hit |
|---|---|
| Protein Concentration | ✘ |
| Protein Localization | ✘ |
| Gene Expression | ✘ |
| Translational Efficiency | ✘ |
Endocytosis
| Temp | Actin Patch (Sac6-tdTomato) | Cortical Patch (Sla1-GFP) | Late Endosome (Snf7-GFP) | Vacuole (Vph1-GFP) |
|---|---|---|---|---|
| 37℃ | ||||
| RT |
Cell Cycle Omics
CYCLoPs (Plb3-GFP)
| Gene / Allele | Actin Patch (Sac6-tdTomato) | Cortical Patch (Sla1-GFP) | Late Endosome (Snf7-GFP) | Vacuole (Sac6-tdTomato) |
|---|
| Gene | Images |
|---|
| Gene | Images |
|---|
Images are not yet available
Images are not yet available